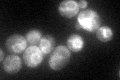
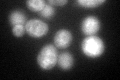

View description
Acyl-coenzymeA:ethanol O-acyltransferase that plays a minor role in medium-chain fatty acid ethyl ester biosynthesis; possesses short-chain esterase activity; localizes to lipid particles and the mitochondrial outer membrane
Localization:
Intensity:
Fold change:
Significance:
-
C’ GFP library in SD
ER72.26 -
N' NOP1pr-GFP in SD

N/A0 -
N' TEF2pr-mCherry in SD

N/A0 -
N' NATIVEpr-GFP in SD

N/A0 -
N' TEF2pr-VC and Cyto-VN in SD

N/A0 -
C’ GFP library in SD+DTT
ER63.410.87No -
C’ GFP library in SD+H2O2

ER87.081.2No -
C’ GFP library in Starvation Media

ER58.050.8No -
C’ GFP library on the background of Pup2-DaMP

ER -
C’ GFP library on the background of CCT mutant

ER71.94510.995468No
